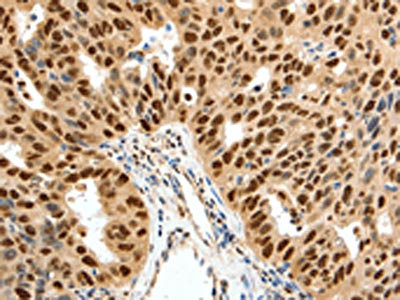

SSB Antibody
-
中文名稱:SSB兔多克隆抗體
-
貨號:CSB-PA924119
-
規格:¥1100
-
圖片:
-
The image on the left is immunohistochemistry of paraffin-embedded Human colon cancer tissue using CSB-PA924119(SSB Antibody) at dilution 1/50, on the right is treated with synthetic peptide. (Original magnification: ×200)
-
The image on the left is immunohistochemistry of paraffin-embedded Human ovarian cancer tissue using CSB-PA924119(SSB Antibody) at dilution 1/50, on the right is treated with synthetic peptide. (Original magnification: ×200)
-
-
其他:
產品詳情
-
Uniprot No.:
-
基因名:
-
別名:Autoantigen La antibody; La antibody; La autoantigen antibody; La autoantigen homolog antibody; La protein antibody; La ribonucleoprotein antibody; La ribonucleoprotein domain family member 3 antibody; LA_HUMAN antibody; LARP3 antibody; Lupus La antigen antibody; Lupus La protein antibody; Lupus La protein homolog antibody; MGC118101 antibody; MGC93380 antibody; mRNA for autoantigen antibody; OTTMUSP00000014043 antibody; RP23 273G23.1 antibody; Sjoegren syndrome type B antigen antibody; Sjogren syndrome antigen B (autoantigen La) antibody; Sjogren syndrome antigen B antibody; SS B antibody; SS-B antibody; SS-B/La protein antibody; SSB antibody
-
宿主:Rabbit
-
反應種屬:Human,Mouse,Rat
-
免疫原:Synthetic peptide of Human SSB
-
免疫原種屬:Homo sapiens (Human)
-
標記方式:Non-conjugated
-
抗體亞型:IgG
-
純化方式:Antigen affinity purification
-
濃度:It differs from different batches. Please contact us to confirm it.
-
保存緩沖液:-20°C, pH7.4 PBS, 0.05% NaN3, 40% Glycerol
-
產品提供形式:Liquid
-
應用范圍:ELISA,IHC
-
推薦稀釋比:
Application Recommended Dilution ELISA 1:2000-1:5000 IHC 1:50-1:200 -
Protocols:
-
儲存條件:Upon receipt, store at -20°C or -80°C. Avoid repeated freeze.
-
貨期:Basically, we can dispatch the products out in 1-3 working days after receiving your orders. Delivery time maybe differs from different purchasing way or location, please kindly consult your local distributors for specific delivery time.
-
用途:For Research Use Only. Not for use in diagnostic or therapeutic procedures.
相關產品
靶點詳情
-
功能:Binds to the 3' poly(U) terminus of nascent RNA polymerase III transcripts, protecting them from exonuclease digestion and facilitating their folding and maturation. In case of Coxsackievirus B3 infection, binds to the viral internal ribosome entry site (IRES) and stimulates the IRES-mediated translation.
-
基因功能參考文獻:
- A cytoplasmic isoform of La protein as well as LARPs 6, 4, and 1 function in mRNA metabolism and translation in distinct but similar ways, sometimes with the poly(A)-binding protein, and in some cases by direct binding to poly(A)-RNA. PMID: 28782243
- our data support a novel model, whereby cancer-associated La protein contributes to cisplatin resistance by stimulating the translation of anti-apoptotic factor Bcl2 in HNSCC cells. PMID: 27105491
- La protein is an important microprocessor component regulating miRNA processing efficiency by association with DGCR8 to regulate formation of the DGCR8-Drosha complex for miRNA processing. PMID: 29087193
- La functions as gatekeeper ensuring correct tRNA maturation and protecting the miRNA pathway from potentially functional tRNA fragments. PMID: 27345152
- Findings identified two novel SUMO acceptors sites on La and suggest that sumoylation of La alters its RNA-binding activity, which could influence a broad range of RNA processing steps where La's function has been implicated. PMID: 27224031
- Binding of double-stranded RNA involves less penetration into the RNA recognition motif (RRM2) binding pocket and more engagement with the unstructured C-terminus of the La C-terminal domain (CTD). PMID: 27959512
- At the 3' UTR, HUR facilitates circularization of the viral genome through interaction with another host factor, La, which is critical for replication. PMID: 26339049
- expression of nuclear hLa Ag induces thymic clonal deletion and tTreg selection, and lymphocytic infiltration of the lung is a consequence of La-specific CD4(+) T cell autoimmunity PMID: 25582858
- Authors provide a model whereby a novel interplay between RNA-binding, RNA chaperoning and AKT phosphorylation of La protein regulates CCND1 IRES-mediated translation. PMID: 25520193
- Primary Sjogren's patients with WSP form a benign subgroup, with a lower prevalence of anti-SSB and extraglandular manifestations. PMID: 24529195
- A beta turn in the human La protein is responsible for the interaction with the hepatitis C virus RNA. PMID: 24478427
- Total IgG levels correlate positively with autoantibodies La, Ro60 and Ro52 but not with RING or B-box domain antibodies of Ro52. PMID: 23554036
- The competition between the host factor (La) and the viral protein (NS3) for binding to HCV IRES might regulate the molecular switch from translation to replication of HCV. PMID: 22355520
- Our study demonstrates that La plays a critical role in regulating HCV replication by interacting with the GCAC motif. PMID: 23552417
- Sjogren syndrome antigen B (SSB)/La promotes global microRNA expression by binding microRNA precursors through stem-loop recognition PMID: 23129761
- Iron promotes the translation initiation of hepatitis C virus by stimulating the expression of eIF3A and La proteins. PMID: 22634302
- oxidants cause nuclear export of La/SSB protein and subsequent association of La/SSB with Nrf2 untranslated regions and ribosomes PMID: 22207702
- data indicate that the JAK2(V617F) mutation affects p53 response to DNA damage through the upregulation of La antigen and accumulation of MDM2 PMID: 21785463
- the structural elements required for La-mediated RNA chaperone activity PMID: 22203678
- La binds to domain IV of the hepatitis C virus RNA using an RNA recognition that is quite distinct from its mode of binding to RNAs with a 3' UUU(OH) trailer. PMID: 22009680
- function of the RNA-binding protein La in promoting tumor progression of head and neck squamous cell carcinoma PMID: 22016766
- Autoantigen La promotes efficient RNAi, antiviral response, and transposon silencing by facilitating multiple-turnover RNA-induced silencing complex catalysis. PMID: 22055194
- Overexpression of mouse or human La enhanced M-MuLV particle release in the absence of glycosylated gag. PMID: 21343359
- La protein binds to and mediates interaction of the 5' and 3' noncoding ends of the Japanese encephalitis virus genome. PMID: 21294637
- show elevated La protein expression in cervical cancer tissue and its correlation with aberrant CCND1 protein levels in cervical tumor tissue lysates PMID: 20856207
- There is a correlation between La protein and HBV mRNA and the expression of HBV protein. PMID: 17064465
- study found expression of La protein is induced by HCV infection, and this induced La protein-activated telomerase activity in a hepatoma cell line; HCV infection might be strongly related to telomerase activity in the liver through La protein induction PMID: 20497049
- nuclear trafficking by La affects the normal order of pre-tRNA processing PMID: 12049746
- molecular characterization of the human La protein.hepatitis B virus RNA.B interaction in vitro PMID: 12121976
- La autoantigen is required for the internal ribosome entry site-mediated translation of Coxsackievirus B3 RNA PMID: 12384597
- binds differentially to multiple sites within the 5' untranslated region of Coxsackievirus B3 RNA PMID: 12457960
- in addition to full-length La protein, both N- and C-terminal halves were able to interact with hepatitis C virus internal ribosome entry site in vivo. PMID: 12540850
- Dengue 4 virus minus strand 3'UTR RNA binds with La protein in human monocytes PMID: 12584332
- Results suggest that La ribonucleoproteins (RNP) exist in distinct states that differ in subcellular localization, serine 366 phosphorylation, and associated RNAs. PMID: 14636586
- La motif adopts an alpha/beta fold that comprises a winged-helix motif elaborated by the insertion of three helices PMID: 15004549
- La protein binds to the 5' end and with the 3' UTR of Dengue virus RNA; interacts with the dengue virus nonstructural proteins NS5 and NS3 PMID: 15084396
- NMR assignment and secondary structure of the La motif PMID: 15213463
- Composition of La/hepatitis B virus ribonucleoprotein particles as well as interacting cellular factors, are critical determinants in the regulation of the stability of the HBV RNA. PMID: 15302879
- RRM1 and La motifs bind pre-tRNA PMID: 15371415
- CK2 is responsible for La S(366) phosphorylation in vivo PMID: 15485924
- Nonphosphorylated SSB interacts with nucleolin at nucleolar sites involved in rRNA biogenesis. PMID: 15572691
- This protein is s host factors responsible for the regulation of the hepatitis C virus internal ribosome entry site. PMID: 15685555
- essential for efficient hepatitis C virus replication PMID: 15823607
- In vitro RNA chaperone activity pf SSB was studied. PMID: 15928345
- nuclear retention of peptidylglycine alpha-amidating monooxygenase (PAM) mRNA is lost upon expressing the La proteins that lack a conserved nuclear retention element, suggesting a direct association between PAM mRNA and La protein in vivo PMID: 16107699
- Anti-La antibodies bound to immunodominant epitopes of La within the NH(2)-terminus and the RNA recognition motif (RRM) region of apoptotic human cells PMID: 16320341
- Here, we show by chromatin immunoprecipitation (ChIP) that La is associated with pol III-transcribed genes in vivo PMID: 16344466
- Results report the crystal structure of the N-terminal domain of human La, consisting of La and RRM1 motifs, bound to RNA. PMID: 16387655
- Changes in salivary production rate are associated with aging and SSB antibodies. PMID: 16467037
- La protein undergoes nucleocytoplasmic shuttling whereas EBER1 and EBER2 noncoding RNA's are confined to the nucleus. PMID: 16682524
顯示更多
收起更多
-
亞細胞定位:Nucleus.
-
數據庫鏈接:
Most popular with customers
-
-
YWHAB Recombinant Monoclonal Antibody
Applications: ELISA, WB, IHC, IF, FC
Species Reactivity: Human, Mouse, Rat
-
Phospho-YAP1 (S127) Recombinant Monoclonal Antibody
Applications: ELISA, WB, IHC
Species Reactivity: Human
-
-
-
-
-